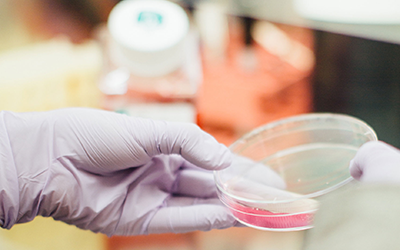
LEO FOUNDATION AWARDS

ESDR Yesterday, Today & Tomorrow
JID has just published a supplement celebrating our half century. From the founding of the association, to major innovations, personal reflections, partnerships and our vision for the future, the issue covers all the important activities of the ESDR during the past 50...
JID 2019 IF
The JID's 2019 Impact Factor reflects the incredible dermatological research from around the world that JID features. Thanks to all authors, reviewers, editors and JID staff!
Welcome to the ESDR Kitchen
ESDR is thrilled to announce the launch of our brand new series of live webinars: ESDR Kitchen. Every second Wednesday at 13.30 (CET) starting 8 July 2020, we will run a live, moderated free webinar on Zoom. One theme out of the following will be cooked during each...
Report your cases of COVID-19 in psoriasis to PsoProtect!
PsoProtect is a global web-based registry for healthcare professionals to report cases of COVID-19 (confirmed or suspected) in psoriasis. Please see below an overview of the current PsoProtect cohort of 146 cases. More detailed summary statistics can be found on...
Report your cases of COVID-19 in AD to SECURE-AD!
SECURE-AD is a a secure, online, de-identified Personal Health Identifier (PHI)-free reporting registry for healthcare professionals to report cases of COVID-19 in their AD patients. We encourage clinicians worldwide to report ALL cases of COVID-19 in their AD...
International Nurses Day
International Nurses Day is celebrated around the world every 12 May, the anniversary of Florence Nightingale’s birth, the founder of modern nursing. 2020 marks the 200th anniversary of her birth, that’s why the World Health Assembly has designated 2020 as...
LEO FOUNDATION AWARDS
Deadline for Applications: 22 June 2020. Applications will shortly open for the 2020 LEO Foundation Awards. If you are resident in an EMEA (Europe/Middle East/Africa) country and meet the eligibility criteria, please submit your application here. One grant of $100,000...
JID REMOTE ACCESS
Members can now access the JID from home by logging into the ESDR site or through JIDonline.org. Please click here for further details.
THE ESDR AND COVID-19 – update
The ESDR and COVID-19 - update 15 April 2020 As the largest investigative dermatology society in Europe, we are taking seriously our responsibilities to protect communities from the COVID-19 pandemic. Concerned by your safety, following the recommendations for...